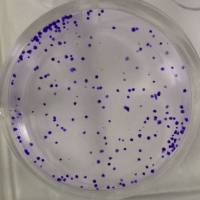
细胞克隆形成实验

transwell侵袭、迁移实验
- ¥500
- Transwell侵袭实验
- 全国
- 2025年07月16日
万千商家帮你免费找货
0 人在求购买到急需产品
- 详细信息
- 询价记录
- 技术资料
- 提供商:
湘元生物
- 服务名称:
transwell侵袭、迁移实验
transwell实验检测细胞迁移是将transwell小室放入培养板中,小室内称为上室,培养板内称为下室,上下层培养液以聚碳酸酯膜相隔, 上室内添加上层培养液,下室内添加下层培养液。将细胞种在上室内,由于膜有通透性,下层培养液中的成分可以影响到上室内的细胞, 从而可以研究下层培养液中的成分对细胞生长、运动等的影响。
Transwell侵袭实验基本原理同迁移实验,只是在聚碳酸酯膜上铺有 Matrigel 胶。Matrigel 是从小鼠EHS肉瘤中提取的基质成分, 含有LN、IV型胶原、接触蛋白和肝素硫酸多糖,铺在无聚乙烯吡硌烷酮的聚碳酸酯滤膜上,能在DMEM培养基中重建形成膜结构, 这种膜结构与天然基质膜结构极为相似。滤膜孔径一般为8 μm,而且膜孔都被Matrigel覆盖, 细胞不能自由穿过,必须分泌水解酶,并通过变形运动才能穿过这种铺有Martrigel的滤膜,这与体内情况较为相似。肿瘤细胞穿过重建基质膜的能力与它的体内侵袭转移能力表现出较好的相关性,可以用重建基质膜模型初筛抗侵袭药物。
实验流程:
1、细胞前处理 ;
2、transwell接种;
3、培养4拍照分析
服务说明:
客户需提供生长状态良好的细胞株及其他专用实验材料,如质粒、病毒、药物等;
实验前,客户需告知具体的细胞处理方式及详细要求。
交付标准:
完整实验报告(包括操作流程、细胞图片及数据分析结果)一份
服务流程:
风险提示:丁香通仅作为第三方平台,为商家信息发布提供平台空间。用户咨询产品时请注意保护个人信息及财产安全,合理判断,谨慎选购商品,商家和用户对交易行为负责。对于医疗器械类产品,请先查证核实企业经营资质和医疗器械产品注册证情况。
- 作者
- 内容
- 询问日期
技术资料暂无技术资料 索取技术资料